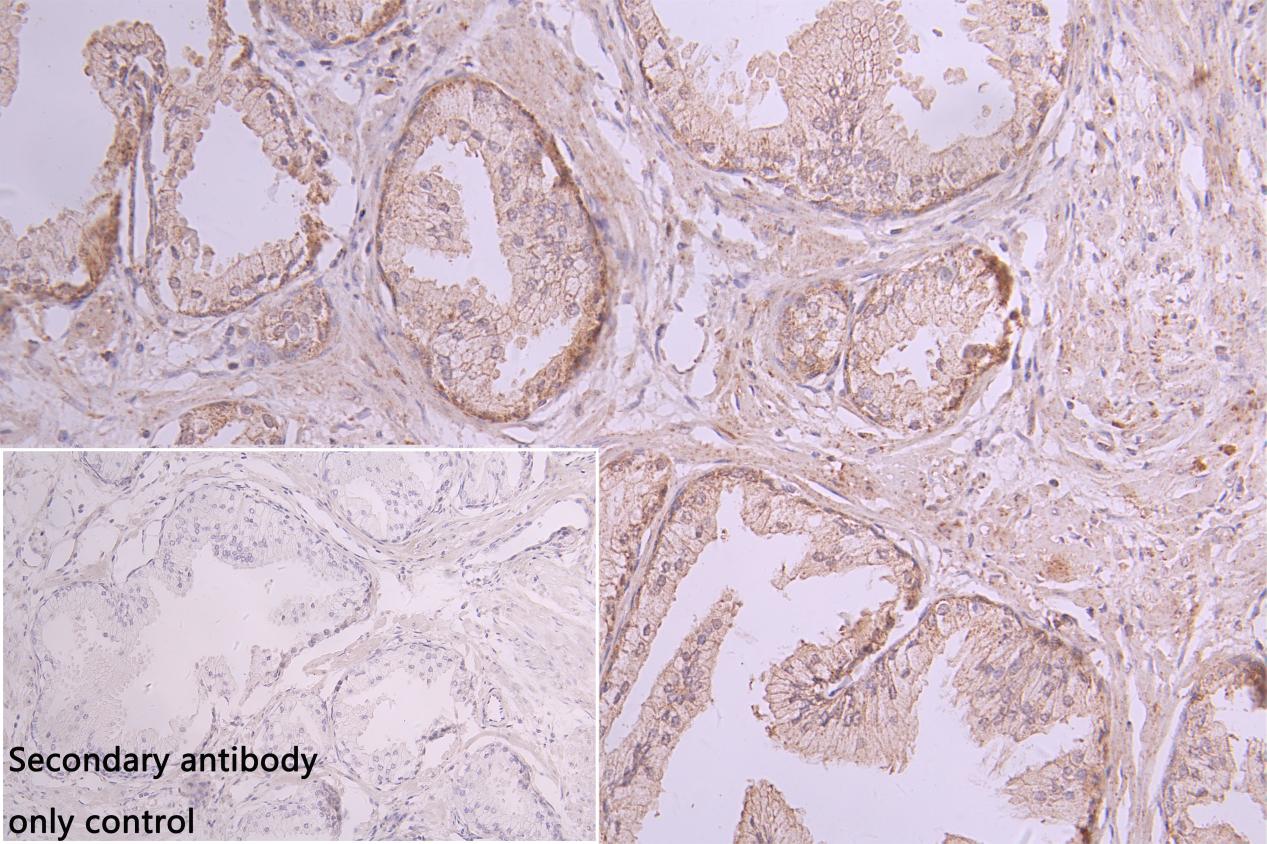
CSB-PA737873LA01HU IHC

15 年
手机商铺
公司新闻/正文
396 人阅读发布时间:2025-06-27 09:22
B7-H6,也称为自然细胞毒性触发受体3配体1(Natural Cytotoxicity Triggering Receptor 3 Ligand 1, NCR3LG1),是B7免疫共刺激/抑制分子家族中一个独特的成员。它不组成性表达于正常组织,但在多种肿瘤细胞表面显著高表达,并可由炎症或感染信号诱导表达于免疫细胞和受损组织细胞。作为自然杀伤细胞(NK)关键活化性受体NCR3(NKp30)的主要功能性配体,B7-H6是介导NK细胞识别“非己”和“危险”信号、启动细胞毒性杀伤的核心分子开关。其在肿瘤免疫逃逸中的核心作用,以及在感染免疫和炎症调节中的潜在功能,使其成为当前肿瘤免疫治疗和免疫调节药物研发的前沿靶点。
1. B7-H6的结构、表达调控与核心功能机制
2. B7-H6与疾病
3. B7-H6的药物研发现状
4. B7-H6靶向治疗的未来展望
5. 华美生物B7-H6相关产品
B7-H6具有典型的B7家族胞外结构域:一个N端免疫球蛋白可变区样结构域(IgV)和一个近膜免疫球蛋白恒定区样结构域(IgC)。IgV结构域是结合NKp30的关键区域,决定了相互作用的特异性和亲和力。其跨膜结构域将其锚定在细胞膜上,胞内结构域较短,提示其信号传递主要依赖于NKp30下游通路。B7-H6与NKp30的结合是高度特异性的,这种相互作用是NK细胞活化的重要触发点。
B7-H6的表达受到严格调控,在正常组织中极少表达,但在特定病理状态下可被多种因素强烈诱导:
● 组成性高表达于多种肿瘤:广泛存在于实体瘤(如结直肠癌、胃癌、卵巢癌、乳腺癌、黑色素瘤、神经母细胞瘤、淋巴瘤、胶质瘤等)和血液肿瘤(如白血病、淋巴瘤)细胞表面,是重要的肿瘤相关抗原。
● 诱导性表达:
(1)治疗与应激诱导: 化疗、放疗、热休克及细胞因子(TNF-α)等治疗/应激因素显著上调B7-H6。
(2)整合应激反应(ISR): 关键诱导通路,由PERK介导eIF2α磷酸化驱动。被特定药物(HIV蛋白酶抑制剂、毒胡萝卜素Tg)和病毒感染(如HCMV)利用。
(3)表观遗传调控: HDAC3上调促进表达(可被HDAC抑制剂阻断);BRD4结合启动子区并与JMJD6协同,招募转录机器促进转录(可被BET抑制剂JQ1阻断)。
(4)转录因子驱动: 癌基因c-Myc直接上调B7-H6表达,两者在多种肿瘤中表达正相关。
(5)炎症信号: TLR配体及炎症因子(TNF-α, IL-1β)可诱导特定免疫细胞(如炎性单核细胞、中性粒细胞)表达。
● 可溶性形式 (sB7-H6):通过蛋白酶切割或选择性剪接产生,存在于血清和体液中。sB7-H6是重要的免疫抑制分子,能竞争性结合NKp30,阻断膜型B7-H6介导的NK细胞活化,其血清水平与肿瘤负荷和不良预后相关。
B7-H6不仅是配体,其表达本身在肿瘤细胞内激活多条关键促生存、增殖和转移的信号通路:
Ras/MEK/ERK通路: B7-H6诱导MEK、ERK和HIF-1α的磷酸化。激活的ERK1/2转位入核,促进癌细胞存活、增殖、迁移和分化。B7-H6下调会抑制该通路。
PI3K/AKT通路: B7-H6激活PI3K/AKT信号。其下调会抑制该通路,影响细胞存活和代谢。
STAT3通路: B7-H6诱导STAT3活化,促进肿瘤发生。其下调会减少RNMT和c-Myc等STAT3下游效应分子的水平。
激活NK细胞杀伤: 肿瘤细胞表面的膜型B7-H6与NK细胞表面的活化性受体NKp30结合,是触发NK细胞杀伤的关键“激活信号”之一。
● 信号转导: 结合导致NKp30胞内区ITAM(免疫受体酪氨酸激活基序)被Src家族激酶磷酸化,进而招募并激活Syk/ZAP70激酶。
● 下游通路激活:
PLCγ 裂解PIP2产生IP3和DAG,导致细胞内Ca2+浓度升高和PKC激活。
PI3K 产生PIP3,激活Akt等效应分子。
激活Vav,进而激活小G蛋白Rac,通过PAK1-MEK-ERK级联激活MAPK通路。
图:B7-H6结合NKp30 诱导细胞裂解示意图 [1]
B7-H6在炎症条件下可被诱导表达于非肿瘤细胞(如CD14⁺CD16⁺促炎单核细胞和中性粒细胞),并分泌可溶性形式(sB7-H6)。在脓毒症中,膜结合型B7-H6(mB7-H6)通过结合NKp30激活NK细胞,加剧早期全身炎症反应综合征(SIRS),导致高死亡率;而外泌体来源的sB7-H6则阻断NKp30信号通路,抑制NK细胞功能,促进代偿性抗炎反应综合征(CARS)阶段的免疫麻痹,同样增加患者死亡风险。革兰阴性菌感染特异性地诱导sB7-H6产生,其机制可能与TLR4-TRIF通路相关。B7-H6的双向免疫调节作用(促炎/抑炎)共同加剧脓毒症病理进程,提示其动态监测可作为脓毒症预后分层的新指标 [2]。
B7-H6在SCLC中呈现独特的双向免疫调节作用 [3]:其高表达与无进展生存期(PFS)延长及免疫浸润增加呈正相关,但与NK细胞活化呈负相关。机制上,B7-H6的膜结合形式可通过结合NKp30激活NK细胞抗肿瘤活性,而可溶性形式则抑制NK功能。相较于PD-L1,B7-H6在SCLC中表达更高且具有肿瘤特异性(正常组织几乎不表达),是极具潜力的免疫治疗新靶点(如ICI、CAR-T等)。但其动态表达模式、化疗响应性及与可溶性形式的平衡需进一步研究。
B7-H6在T-LBL中首次被发现存在核转位现象(依赖核定位信号NLS及转运蛋白XPO-5/6),其表达与乳酸脱氢酶升高、ECOG评分、B症状等不良预后因素显著相关,但受强化化疗方案影响未直接关联患者生存率 [4]。功能上,B7-H6通过双重机制驱动疾病:① 膜/质型B7-H6(占比38.5%)可作为免疫治疗靶点(NKp30-CAR-T体外有效清除肿瘤);② 细胞核型B7-H6可能通过非免疫途径(如调控RAG-1基因)促进肿瘤发生,组蛋白去乙酰化酶抑制剂可抑制其表达。研究表明B7-H6是T-LBL潜在预后标志物及治疗靶标,但其促肿瘤机制需进一步解析。
B7-H6在B细胞淋巴瘤中高表达且驱动恶性进展:其敲除通过抑制STAT3通路(降低STAT3/ERK1/2磷酸化)显著抑制肿瘤增殖(下调Survivin/PCNA/c-Myc)、阻滞G0/G1期(调控Cyclin D1-CDK4/6-Rb-p21轴)、促进凋亡(降低Bcl-2/Bcl-xL、升高Bax/Bad、激活Caspase-8/3)并增强化疗敏感性;同时抑制转移(下调MMP-2/9)。研究表明B7-H6通过STAT3信号轴协同调控淋巴瘤核心恶性表型,是潜在治疗靶点 [5]。
B7-H6在HCC中的表达与肿瘤体积正相关,低mRNA水平预示更好生存率 [6];功能上,敲除B7-H6可显著抑制HCC细胞增殖、迁移和侵袭,阻滞细胞周期于G1期,并下调癌基因c-Myc/c-Fos及周期蛋白cyclin D1。机制上,B7-H6通过NKp30互作在HBV相关炎症微环境中加剧肝损伤(如IL-32上调),同时直接调控肿瘤生物学行为,提示其兼具炎症介导与癌基因双重角色,是HCC潜在预后标志物及免疫治疗靶点(如B7-H6-CAR-T)。
根据数据库显示,B7-H6靶向药物的研发现状仍处于早期临床验证和适应症探索扩展阶段。其中,进展最快的是由勃林格殷格翰(Boehringer Ingelheim GmbH)开发的BI 765049,目前处于临床I期。BI 765049是一种新型免疫球蛋白G(IgG)样T细胞衔接器(TcE)(双特异性抗体),其作用机制是通过同时结合T细胞表面的CD3和肿瘤细胞表达的B7-H6,激活T细胞并诱导其对肿瘤细胞的杀伤,目前主要在以胃癌、结直肠癌等B7-H6高表达率的消化道肿瘤中进行临床探索。此外,靶向B7-H6的嵌合抗原受体T细胞疗法疗法(例如CAR-T和CAR-NK)以及单抗药物也在进一步验证中。
| 药物 | 药物类型 | 适应症 | 在研机构 | 最高研发阶段 |
| BI-765049 | 双特异性T细胞结合器 | 结肠癌、胰腺导管腺癌、直肠癌、胃癌、头颈部肿瘤、肝癌、非小细胞肺癌、胰腺癌、晚期恶性实体瘤、转移性结直肠癌 | Boehringer Ingelheim GmbH | 临床I期 |
| B7-H6 Targeted CAR-T(Adicet) | CAR-T | 肿瘤 | Adicet Bio, Inc. | 临床前 |
| WO2023104062 | 单克隆抗体 | 感染、肿瘤 | Hefei TG ImmunoPharma Co., Ltd 肥天港免疫药物有限公司 |
药物发现 |
| WO2023147404 | CAR-NK | 免疫系统疾病、感染、肿瘤 | Rutgers State University of New Jersey | 药物发现 |
表 B7-H6药物研发管线(数据来源于Pharmsnap)
B7-H6作为肿瘤特异性抗原(正常组织低表达、肿瘤高表达),是癌症免疫治疗的理想靶点。未来需多维度推进其靶向治疗:优化CAR-T/CAR-NK疗法(如CAR-NK避免T细胞自相残杀,优化CAR结构增强特异性与功能);联合化疗/放疗诱导肿瘤B7-H6表达以提升敏感性;深入解析其调控机制(如MYC等转录因子作用)、B7H6/NKp30轴及膜/可溶性形式与免疫微环境互作;加速BiTE/ITE等新型疗法的临床转化(如ITE与抗PD-1联合试验);最终推动其从临床前研究向高效低毒的癌症治疗方案跨越。
华美生物提供B7-H6相关高质量重组蛋白和抗体,旨在帮助科研工作者进行B7-H6作用机制与临床转化方向的研究:
● B7-H6重组蛋白
Recombinant Human Natural cytotoxicity triggering receptor 3 ligand 1 (NCR3LG1), partial, Biotinylated (Active); CSB-MP737873HU-B


Recombinant Human Natural cytotoxicity triggering receptor 3 ligand 1 (NCR3LG1), partial (Active); CSB-BP737873HU


Recombinant Macaca fascicularis natural cytotoxicity triggering receptor 3 ligand 1 (NCR3LG1), partial (Active); CSB-MP4942MOV



Recombinant Macaca fascicularis natural cytotoxicity triggering receptor 3 ligand 1 (NCR3LG1), partial (Active); CSB-MP4942MOVd9


● B7-H6抗体
NCR3LG1 Recombinant Monoclonal Antibody; CSB-RA737873MA1HU


NCR3LG1 Antibody; CSB-PA737873LA01HU

参考文献:
[1] Lee S, Kim JH, Jang IH, et al. Harnessing B7-H6 for Anticancer Immunotherapy: Expression, Pathways, and Therapeutic Strategies. Int J Mol Sci. 2024;25 (19).
[2] Matta J, Baratin M, Chiche L, et al. Induction of B7-H6, a ligand for the natural killer cell-activating receptor NKp30, in inflammatory conditions. Blood. 2013;122 (3):394-404.
[3] Thomas PL, Groves SM, Zhang YK, et al. Beyond Programmed Death-Ligand 1: B7-H6 Emerges as a Potential Immunotherapy Target in SCLC. J Thorac Oncol. 2021;16 (7):1211-1223.
[4] Yuan L, Sun L, Yang S, et al. B7-H6 is a new potential biomarker and therapeutic target of T-lymphoblastic lymphoma. Ann Transl Med. 2021;9 (4):328.
[5] Wu F, Wang J, Ke X. Knockdown of B7-H6 inhibits tumor progression and enhances chemosensitivity in B-cell non-Hodgkin lymphoma. Int J Oncol. 2016;48 (4):1561-70.
[6] Chen L, Feng J, Xu B, et al. B7-H6 expression in human hepatocellular carcinoma and its clinical significance [corrected]. Cancer Cell Int. 2018;18:126.